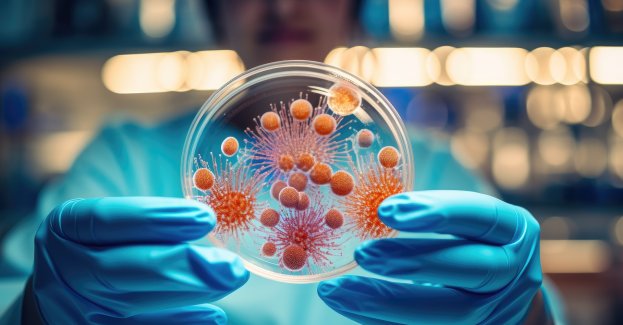

Rząd pracuje nad nowymi warunkami testowania pojazdów autonomicznych. Do dopuszczenia ich do ruchu jeszcze daleka droga
Dużo bardziej liberalne w podejściu do autonomicznych pojazdów są Stany Zjednoczone. Od 2018 roku samochody takie mogą przewozić pasażerów w Kalifornii, a Google oferuje darmowe przejazdy dla mieszkańców w Arizonie. Kilka dni temu Elon Musk zapowiedział uruchomienie usługi robotaxi w Austin w stanie Teksas. Pierwsze jego taksówki bez kierowcy przewiozą pasażerów już w czerwcu. Tesla planuje szybko rozszerzyć usługi na inne miasta w USA i poza nimi. W Austin działa także inna firma oferująca przejazdy autonomicznymi autami – Waymo. W czerwcu planuje ona uruchomić jednak pełny zakres usług.W Polsce od 2018 roku istnieją przepisy, na bazie których można testować pojazdy autonomiczne na drogach, natomiast dopuszczenie ich do ruchu jeszcze nie jest możliwe. Uwarunkowane jest to przepisami Unii Europejskiej, więc prace się toczą w Brukseli, ale też w Genewie, w grupach ONZ, myślę, że z upływem kolejnych lat będą coraz doskonalsze. Na razie możemy się spodziewać pilotaży na obszarach zamkniętych od ruchu publicznego i takie działania się toczą, m.in. w Gdańsku, Krakowie, natomiast na komercyjne wykorzystanie musimy jeszcze poczekać – mówi agencji Newseria prof. Marcin Ślęzak, dyrektor Instytutu Transportu Samochodowego.
Z danych Amerykańskiego Urzędu ds. Bezpieczeństwa Ruchu Drogowego (NHTSA) wynika, że w latach 2019–2024 (do 17 czerwca) w USA odnotowano łącznie niemal 4 tys. wypadków z udziałem samochodów autonomicznych. Najwięcej zdarzeń miało miejsce w 2022 roku. 10 proc. wypadków kończyło się obrażeniami, a w 2 proc. przypadków były ofiary śmiertelne. W marcu 2018 roku autonomiczny pojazd testowy Ubera potrącił i zabił pieszą w Tempe w Arizonie. Był to pierwszy odnotowany przypadek śmiertelnego wypadku z udziałem pieszego, w którym uczestniczył w pełni autonomiczny pojazd. Kierowca rezerwowy pojazdu Ubera został później oskarżony o nieumyślne spowodowanie śmierci. Dużo kontrowersji wzbudzają systemy autopilota montowane w pojazdach Tesli. W 2019 roku kierowca tesli model X zginął w wypadku, w którym po włączeniu autopilota pojazd zjechał z pasa i zaczął przyspieszać, uderzając w barierę przy prędkości ok. 110 km/h.W kwestii wdrożenia technologii pojazdów autonomicznych w Polsce mamy do czynienia z trzema elementami. Jeden to jest oczywiście technologia pojazdów – ona jest rozwijana i doskonalona. Drugi obszar to są uczestnicy ruchu drogowego i tu musimy popracować nad świadomością, żeby ludzie nie obawiali się poruszać takim pojazdem czy też kontaktu na ulicach z takim pojazdem. Trzeci element to infrastruktura, która nie jest niezbędna do wdrożenia tej technologii, ale może bardzo pomóc. Może spowodować, że ta technologia będzie bardziej skuteczna, bo będzie umożliwiała komunikację pojazd–pojazd, pojazd–infrastruktura, w związku z tym możemy więcej informacji przetwarzać i bardziej zadbać o bezpieczeństwo pojazdu i pasażerów na jego pokładzie – wymienia prof. Marcin Ślęzak.
Eksperci ITS przekonują, że dzięki inteligentnym pojazdom liczba wypadków na drogach może się jednak zmniejszyć o ok. 30 proc. W odniesieniu do statystyk za 2023 rok oznaczałoby to 6 tys. wypadków mniej, redukcję ofiar o 500 osób i wielomiliardowe oszczędności z tytułu następstw tych zdarzeń. Z analiz Polskiego Obserwatorium Bezpieczeństwa Ruchu Drogowego ITS wynika bowiem, że w około 90 proc. wypadków na drodze decydującą rolę odgrywa czynnik ludzki.
Edukacja jest o tyle istotna, że – jak wynika z badań przytaczanych przez ITS – nawet wtedy, gdy kierowca jest uważny, a konieczność przejęcia kontroli jest przewidywalna i oczekiwana, to odzyskanie właściwej kontroli nad pojazdem trwa średnio 10 s, a w warunkach rozproszonej uwagi czas reakcji wydłuża się niemal czterokrotnie.W miarę postępu lat pojazdy są wyposażane w coraz więcej systemów wspomagających kierowcę, problem w tym, że one działają w różnym stopniu i nie zwalniają kierowców z uwagi. Często jest tak, że wiedza o tym, w jaki sposób te systemy działają albo kiedy nie zadziałają, nie jest przekazywana kierowcom i to powoduje nadmierne poczucie pozornego bezpieczeństwa. Więc na pewno musimy popracować nad edukacją w zakresie wykorzystywania tych systemów, ale też ustandaryzowaniem ich w taki sposób, żeby z jednej strony nie wywoływały zbyt wielu fałszywych alarmów, które mogą zniechęcać do tych systemów, a z drugiej strony, żeby w sytuacjach rzeczywistego zagrożenia informowały i reagowały, żeby zabezpieczyć pojazd, kierowcę i innych uczestników ruchu drogowego – podkreśla dyrektor ITS.
Jak wynika z ubiegłorocznego badania ITS, przeprowadzonego w ramach projektu Trustonomy wśród menedżerów flot samochodowych i kierowców, 80 proc. z nich nie wie, jak prawidłowo stosować systemy wspomagające kierowcę (ADAS, Advanced Driver Assistance Systems). Jedynie 6 proc. przeszło szkolenie z ich obsługi, a 53 proc. uczyło się jej metodą prób i błędów, co jest sprzeczne z celami stosowania ADAS.
Mimo wątpliwości związanych z bezpieczeństwem i wyzwaniami dotyczącymi edukacji, pojazdy autonomiczne z pewnością stanowią przyszłość transportu, zwłaszcza w dobie problemów z obsadzaniem wakatów zawodowych kierowców. Mogą one też zapewnić mobilność osobom, które nie są w stanie prowadzić samochodu ze względu na wiek czy niepełnosprawność. Kolejną zaletą jest większa efektywność transportu. Obecnie typowy prywatny samochód przez 95 proc. czasu stoi zaparkowany.
Według Fortune Business Insights światowy rynek samochodów autonomicznych został w 2022 roku wyceniony na 1,5 bln dol. Do końca tej dekady jego wartość zwiększy się aż dziewięciokrotnie – do ponad 13,6 bln dol.Pojazdy autonomiczne mogą być też odpowiedzią na problem wykluczenia komunikacyjnego, czyli tam, gdzie nie dojeżdżają autobusy, pojazd na żądanie może dojechać i zabrać pasażera. Ale też mogą być odpowiedzią na problem pijanych kierowców. Możemy w jedną stronę pojechać takim pojazdem, a w drugą wrócić już w trybie autonomicznym i wtedy nie narażamy i siebie, i uczestników ruchu drogowego na niebezpieczeństwo – zauważa ekspert.